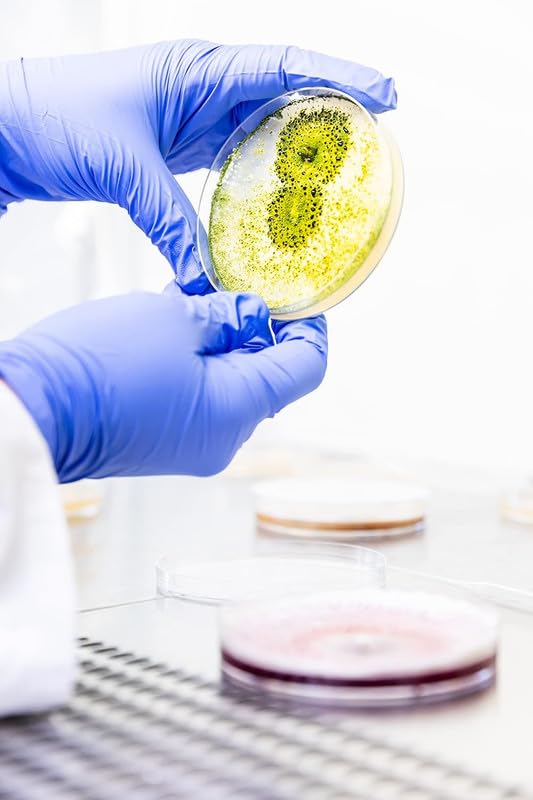

Description
Membrane Cellulose Nitrate 0.22 UM

Applications
- General Filtration
- Medical Assays
- Food, beverage, and pharmaceutical processing
- HPLC Sample Preparation
- Sterilize and clarify aqueous and organic solvent solutions
Product description
Cellulose Nitrate Membrane Filter Paper – 47 mm Diameter, 0.22μm Pore Size, Pack of 100, Biological Filters.Laboratory Filtration Microfiltration Particle Retention Filter Media Filtration Membrane Scientific Research Lab Equipment.
FEATURE
- Sterilize biological solutions/buffers, and vacuum degassing
- Diameter:47mm,pore size:0.22um,100/pack
- strong filters for cell culture provide 4 effective filtration for a wide variety of sample types.
- Cellulose Nitrate Membrane Filter Paper
SPECIFICATION
Sterile, gridded membrane filters are widely used for routine microbiological quality control due to the benefits they offer. Whether single-packed or dispenser-ready, the membrane filters are ready-to-use and each filter is individually packed, offering highest security whilst saving preparatory time. Each individual envelope is marked with the filter identification and lot number.
The membrane filters are available in different pore sizes and three different material types. Cellulose nitrate filters (mixed cellulose ester) contain a mixture of cellulose nitrate and cellulose acetate, a material which assures effective retention combined with high flow rates and optimal colony growth. Cellulose acetate combines high flow rates and thermal stability with very low adsorption characteristics. The various filter colors allow the best possible contrast to the colonies for easy and reliable quantification and identification.
- Outstanding recovery rates for microorganisms
- 0.22 µm filters acc. to ISO 7704
- High flow membranes available
- Three different colors
- Various pore sizes
- Certified quality
- Gamma irradiated at 25 kGray